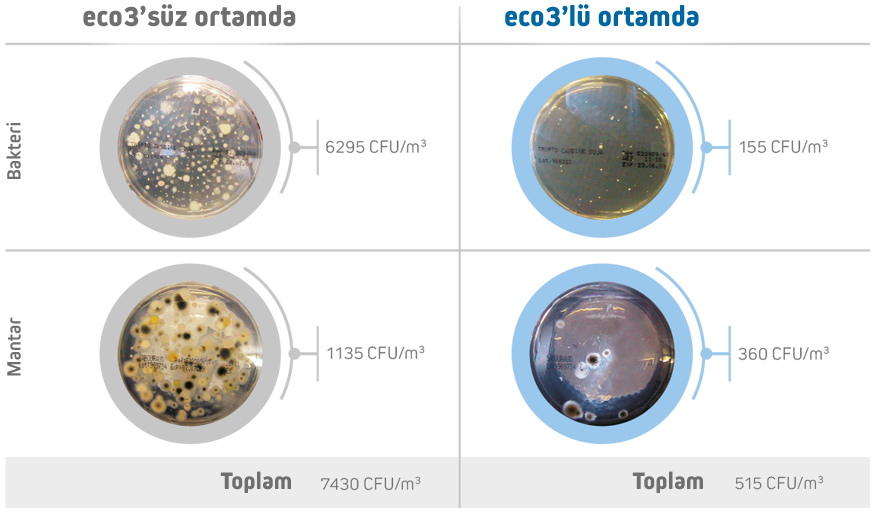

% 99,7 KANITLANMIŞ ETKİNLİK
Hispacold, otobüs ve yolcu taşıma araçlarının iç ortamındaki hava kalitesini iyileştirmek amacıyla SARS-CoV-2 dahil virüsleri, mikroorganizmaları, mikropları ve alerjenleri yok eden ve kötü kokuları önleyen bir Profesyonel Hava Dezenfeksiyon Sistemi olan eco₃'ü geliştirmiştir.
(INTA) Ulusal Havacılık ve Uzay Teknolojisi Enstitüsü (Nükleer, Biyolojik, Kimyasal) NBQ Savunma Sistemleri Dairesi Biyolojik Savunma Birimi tarafından eco₃ Profesyonel Hava Dezenfeksiyon Sistemi ile donatılmış 15 metrelik bir araçta MS2 virüsü varlığında gerçekleştirilmiş testlerdir.
INTA VE SGS TARAFINDAN TEST EDİLMİŞTİR
eco₃ Profesyonel Hava Dezenfeksiyon Sistemi, kurulumu yapılmış araçlarda kendini kanıtlamıştır. Verimliliği, denetim, doğrulama, test ve belgelendirmede dünya lideri olan SGS tarafından test edilmiş olup ve İspanya Hükümeti Savunma Bakanlığı'na bağlı olan INTA Ulusal Havacılık ve Uzay Teknolojisi Enstitüsü, (Nükleer, Biyolojik, Kimyasal) NBQ Savunma Sistemleri Dairesi tarafından onaylanmıştır.

(INTA) Ulusal Havacılık ve Uzay Teknolojisi Enstitüsü (Nükleer, Biyolojik, Kimyasal) NBQ Savunma Sistemleri Dairesi Biyolojik Savunma Birimi tarafından eco₃ Profesyonel Hava Dezenfeksiyon Sistemi ile donatılmış 15 metrelik bir araçta MS2 virüsü varlığında gerçekleştirilmiş testlerdir.

eco₃ klima ünitesinin emiş kısmına yerleştirilir ve klima ünitesi her çalıştığında otomatik olarak çalışmaya başlar. (AC (soğutma), ısıtma, havalandırma). Tüm bu avantajları önemsenmeyecek bir ek elektrik tüketimi ile sağlar.
YOLCULAR ARAÇ İÇİNDE MEVCUTKEN DEZENFEKSİYON
Diğer temizleme ve dezenfeksiyon sistemlerinden farklı olarak eco₃, işlevini yolcular mevcutken ve araç hareket halindeyken gerçekleştirerek kullanımını optimize edecek şekilde tasarlanmıştır. eco₃ Profesyonel Hava Dezenfeksiyon Sistemi mantar, bakteri, virüs, uçucu organik bileşikler, alerjenleri vb., önemli ölçüde azaltır.

Otobüs ve yolcu taşıma araçlarında gerçekleştirilen gerçek test sonuçları
Kültürler, eco₃ Profesyonel Hava Dezenfeksiyon Sistemi bulunan ve eco₃ Profesyonel Hava Dezenfeksiyon Sistemi bulunmayan araçlardan alınmıştır. eco₃ Profesyonel Hava Dezenfeksiyon Sistemi ile, toplam bakteri koloni oluşturan birim sayısı (CFU / m3)% 93 oranında azaltılırken, virüse karşı etkinlik sağlayıcı plak oluşturan birimleri (PFU/m3) % 99,7'ye yükseltir.
*Optimum büyüme sıcaklığı 20 °C ile 45 °C arasında olduğunda aerobik mezofilik flora kabul edilir.
UNE 100012: 2005 standardına göre, 800 CFU/m3 toplam mezofilik aerobik floranın* altındaki sayılar, iç ortam havasında önerilen maksimum değerler olarak kabul edilir ve bunun üzerinde düzeltici önlemlerin alınması tavsiye edilir.
Kaliteli hava, sağlığımız ve çevremiz için vazgeçilmez bir gerekliliktir.






